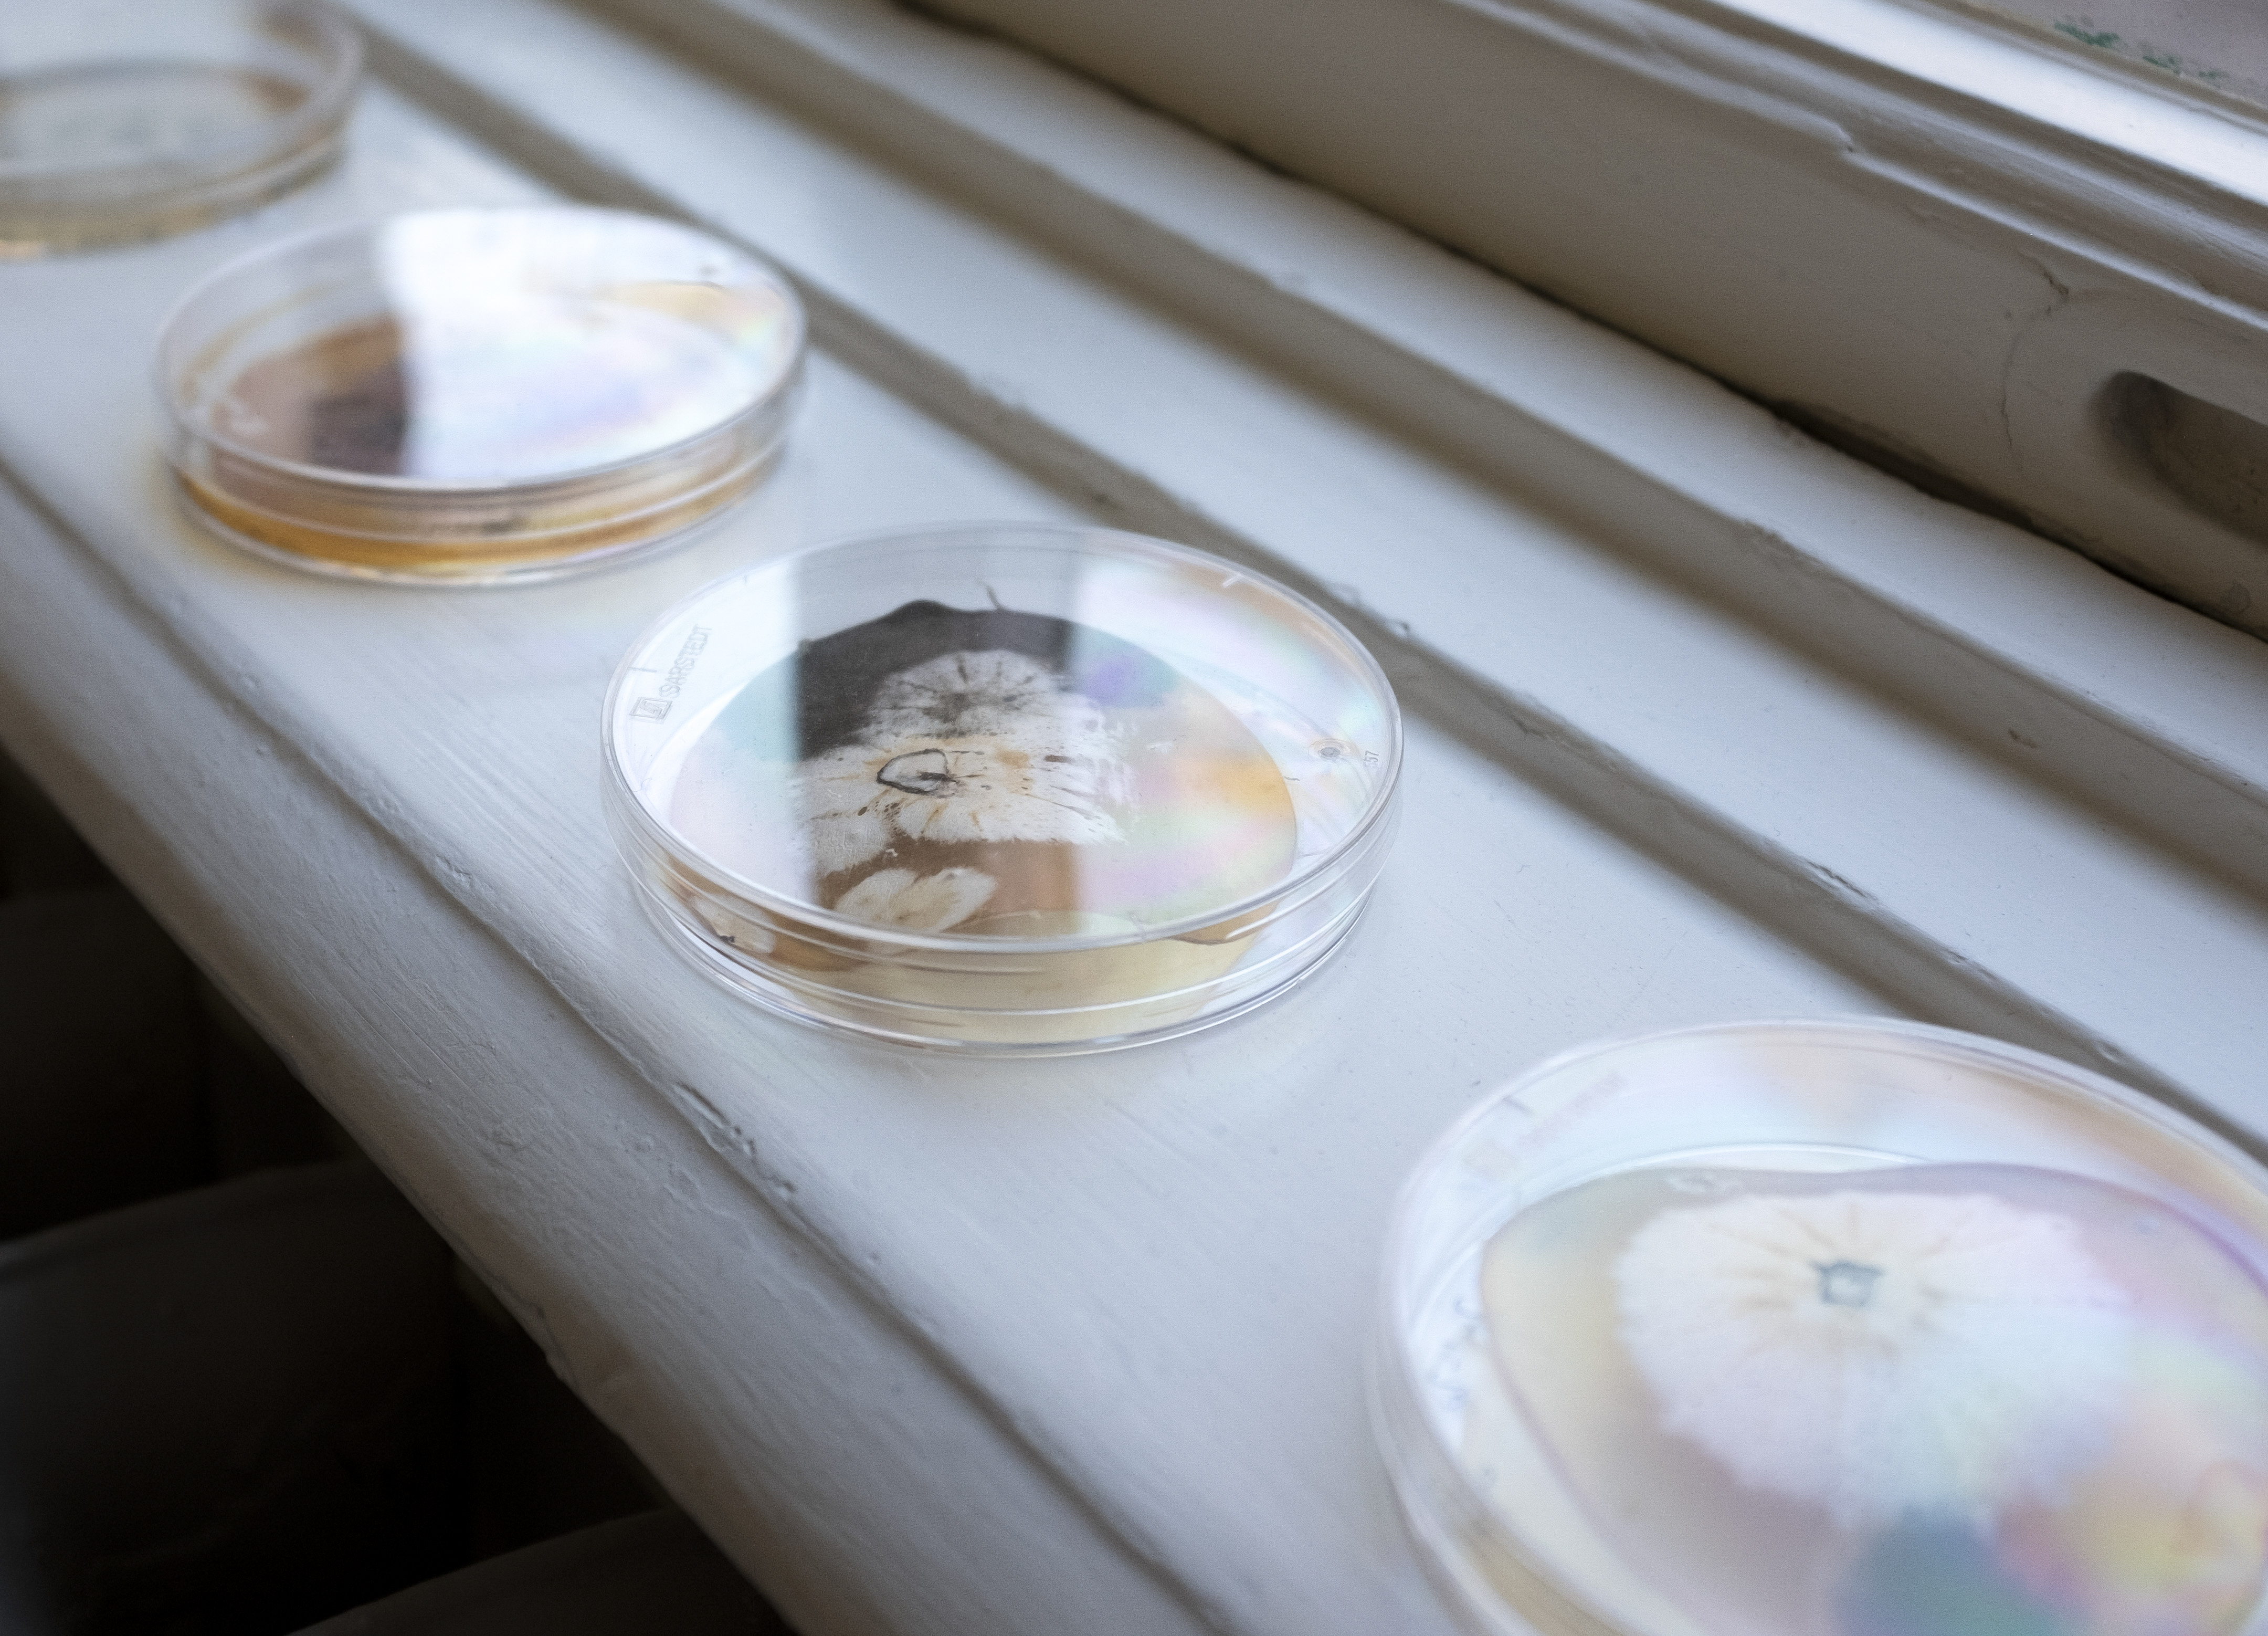

Works - Exhibitions - Workshops / Talks - Read / Hear - Shop - About - Bio / CV
WEST END Projekt
WEST END Projekt, West Einde 58, The Hague, November 27th 2020 - Februari 9th 2021.

This is a podcast by Wim en Sjimmie, called Ezelsoren. They open-mindedly analyze exhibitions and art works without any prior knowledge. Have fun listening!
